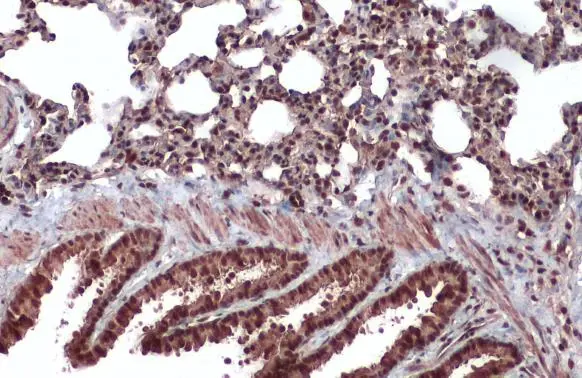
CrkRS antibody detects CrkRS protein at nucleus by immunohistochemical analysis. Sample: Paraffin-embedded mouse lung. CrkRS stained by CrkRS antibody (GTX130809) diluted at 1:500. Antigen Retrieval: Citrate buffer, pH 6.0, 15 min

![Whole cell extract (30 μg) was separated by 5% SDS-PAGE, and the membrane was blotted with CrkRS antibody [HL3756] (GTX641955) diluted at 1:1000. The HRP-conjugated anti-rabbit IgG antibody (GTX213110-01) was used to detect the primary antibody. Whole cell extract (30 μg) was separated by 5% SDS-PAGE, and the membrane was blotted with CrkRS antibody [HL3756] (GTX641955) diluted at 1:1000. The HRP-conjugated anti-rabbit IgG antibody (GTX213110-01) was used to detect the primary antibody.](https://www.genetex.com/upload/website/prouct_img/normal/GTX641955/GTX641955_T-45670_20250207_WB_R_25021320_294.webp)
Whole cell extract (30 μg) was separated by 5% SDS-PAGE, and the membrane was blotted with CrkRS antibody [HL3756] (GTX641955) diluted at 1:1000. The HRP-conjugated anti-rabbit IgG antibody (GTX213110-01) was used to detect the primary antibody.
CDK12 antibody [HL3756]
GTX641955
ApplicationsWestern Blot
Product group Antibodies
ReactivityHuman, Mouse, Rat
TargetCDK12
Overview
- SupplierGeneTex
- Product NameCDK12 antibody [HL3756]
- Delivery Days Customer9
- Application Supplier NoteWB: 1:500-1:3000. *Optimal dilutions/concentrations should be determined by the researcher.Not tested in other applications.
- ApplicationsWestern Blot
- CertificationResearch Use Only
- ClonalityMonoclonal
- Clone IDHL3756
- Concentration1 mg/ml
- ConjugateUnconjugated
- Gene ID51755
- Target nameCDK12
- Target descriptioncyclin dependent kinase 12
- Target synonymsCRK7, CRKR, CRKRS, cyclin-dependent kinase 12, CDC2-related protein kinase 7, Cdc2-related kinase, arginine/serine-rich, cell division cycle 2-related protein kinase 7, cell division protein kinase 12
- HostRabbit
- IsotypeIgG
- Protein IDQ9NYV4
- Protein NameCyclin-dependent kinase 12
- Scientific DescriptionEnables RNA polymerase II CTD heptapeptide repeat kinase activity and cyclin binding activity. Involved in several processes, including positive regulation of transcription elongation by RNA polymerase II; protein autophosphorylation; and regulation of MAP kinase activity. Located in nuclear speck. Part of cyclin K-CDK12 complex. Biomarker of gastric adenocarcinoma; hepatocellular carcinoma; and stomach cancer. [provided by Alliance of Genome Resources, Feb 2025]
- ReactivityHuman, Mouse, Rat
- Storage Instruction-20°C or -80°C,2°C to 8°C
- UNSPSC41116161
![Various whole cell extracts (30 μg) were separated by 5% SDS-PAGE, and the membrane was blotted with CrkRS antibody [HL3756] (GTX641955) diluted at 1:1000. The HRP-conjugated anti-rabbit IgG antibody (GTX213110-01) was used to detect the primary antibody. Corresponding RNA expression data for the same cell lines are based on Human Protein Atlas program. Various whole cell extracts (30 μg) were separated by 5% SDS-PAGE, and the membrane was blotted with CrkRS antibody [HL3756] (GTX641955) diluted at 1:1000. The HRP-conjugated anti-rabbit IgG antibody (GTX213110-01) was used to detect the primary antibody. Corresponding RNA expression data for the same cell lines are based on Human Protein Atlas program.](https://www.genetex.com/upload/website/prouct_img/normal/GTX641955/GTX641955_T-45670_20250207_WB_TPM_watermark_25021320_582.webp)
![Whole cell extract (30 μg) was separated by 5% SDS-PAGE, and the membrane was blotted with CrkRS antibody [HL3756] (GTX641955) diluted at 1:1000. The HRP-conjugated anti-rabbit IgG antibody (GTX213110-01) was used to detect the primary antibody. Whole cell extract (30 μg) was separated by 5% SDS-PAGE, and the membrane was blotted with CrkRS antibody [HL3756] (GTX641955) diluted at 1:1000. The HRP-conjugated anti-rabbit IgG antibody (GTX213110-01) was used to detect the primary antibody.](https://www.genetex.com/upload/website/prouct_img/normal/GTX641955/GTX641955_T-45670_20250207_WB_M_25021320_394.webp)




![Lane 1: Marker [kDa] 250, 130, 95, 72, 55, 36, 28, 17, 10 | Lane 2: RT4 | Lane 3: U-251 MG | Lane 4: Human Plasma | Lane 5: Liver | Lane 6: Tonsil](https://atlasantibodies.s3.amazonaws.com/images/wb/hpa073305-wb-1.jpg)